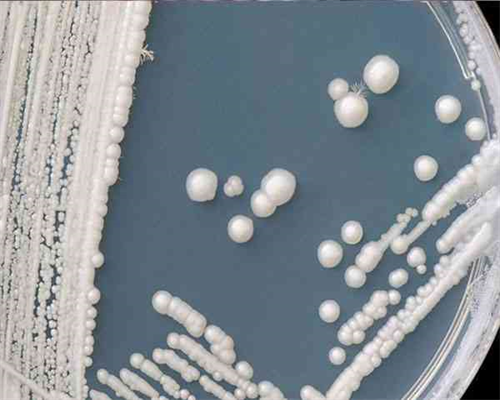
试管婴儿助孕怎么调节好激素内分泌~合法助孕套餐

试管婴儿助孕怎么调节好激素内分泌~合法助孕套餐......
来源:未知 阅读量:780时间:2025-10-28
内分泌激素水平的好坏在一定程度上将左右试管婴儿最终成功率,所以调节好自身的激素水平后再试管可以大大提高试管的成功率。
医生诊断:
合适时间检查激素6项水平,甲状腺功能五项(不是特别重要),AMH值,了解自己的身体情况后才能因症施策,找准病因,将激素水平调节到正常标准,这样就可以毫无心里负担的去乌克兰做第三代试管了。
生活方面:
1、食物、保健调理:
试管前男女方都要吃叶酸、维E,以提高精子和卵子的质量。如果女方年纪大,或者卵巢功能欠佳(FSH高于9),吃点DHEA(有子宫肌瘤、多囊卵巢综合症者不宜吃);
食物种类要多样,搭配要合理,多吃蔬菜和水果,少吃油腻和刺激性食物。应注意保持粪便、尿液和汗腺正常,以便身体产生的所有废物和毒素能够顺利排出。应注意及时补充饮用水和防治便秘等症状;
可适当多吃一点蛋白质高的食物卵泡会长的好,如:牛奶、黄豆、鱼、虾、蛋类等;
2、情绪舒张:
心情好坏是影响女性内分泌水平的重要因素。在平时生活工作中要懂得释放压力,保持愉快乐观的心情,保持平和的心态也是调节内分泌的一种方式。
心大一点,焦虑解决不了任何问题
女性应该特别注意放松身心,减轻心理压力,克服焦虑、紧张和其他负面情绪,努力提高自我控制能力,避免一切负面心理刺激,如恐慌、愤怒和过度悲伤。
3、运动调节、安排好作息:
运动可以调节内分泌,保持健康。通常,人们注重户外运动,积极参加健身活动。每天跑步、快步走或者跳绳30分钟-1个小时(避开月经期),血液循环对生殖系统和胚胎着床非常重要。
日常工作和休息应该按时完成,以实现工作和休息的结合。尤其需要控制夜生活,应该积极保证充足的睡眠。
最新文章
友情链接:

Copyright © 2002-2030 沪ICP备2024069976号-1 上海必为投资管理有限公司 上海市闵行区元江路5500号第1幢6024室上海试管中心版权所有